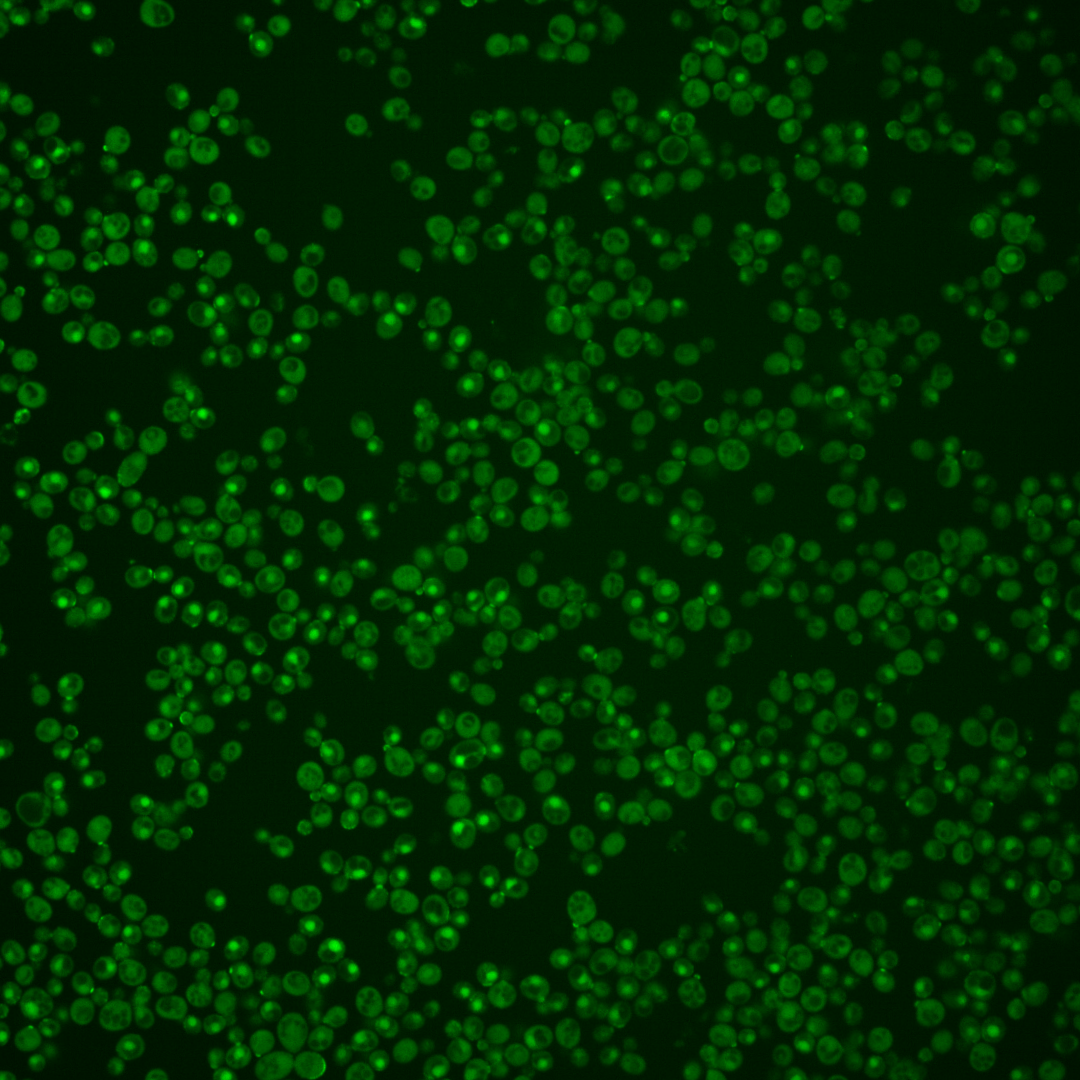
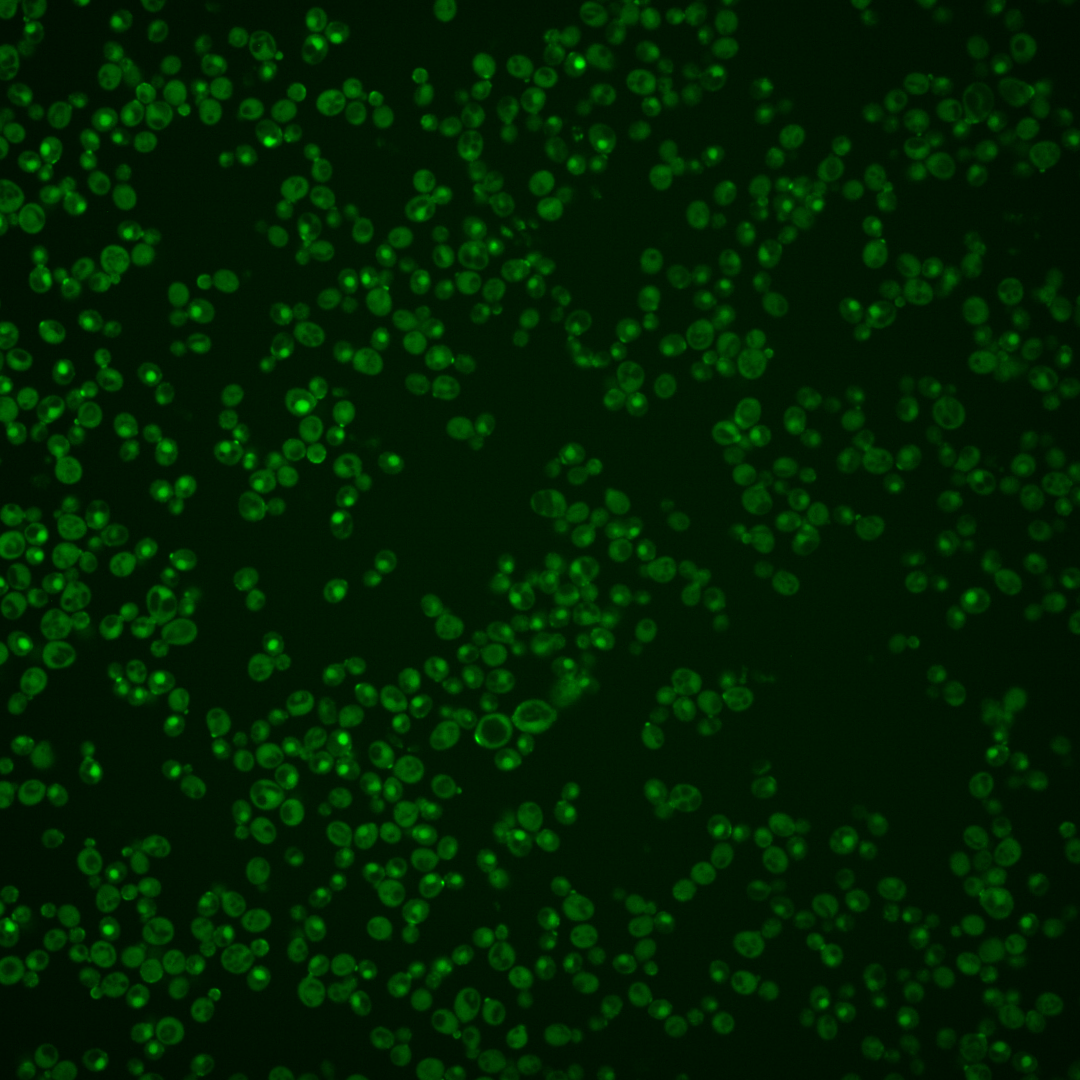
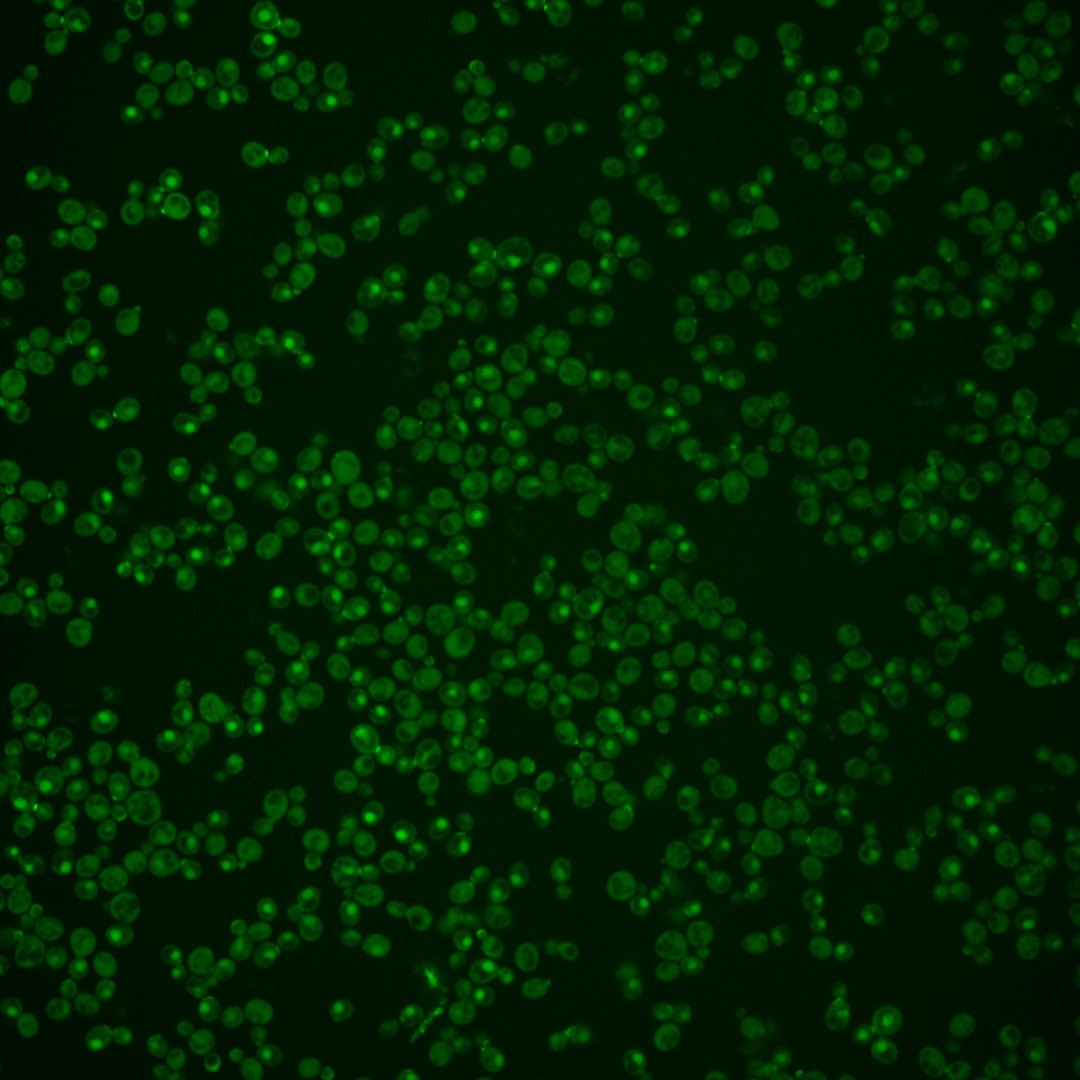
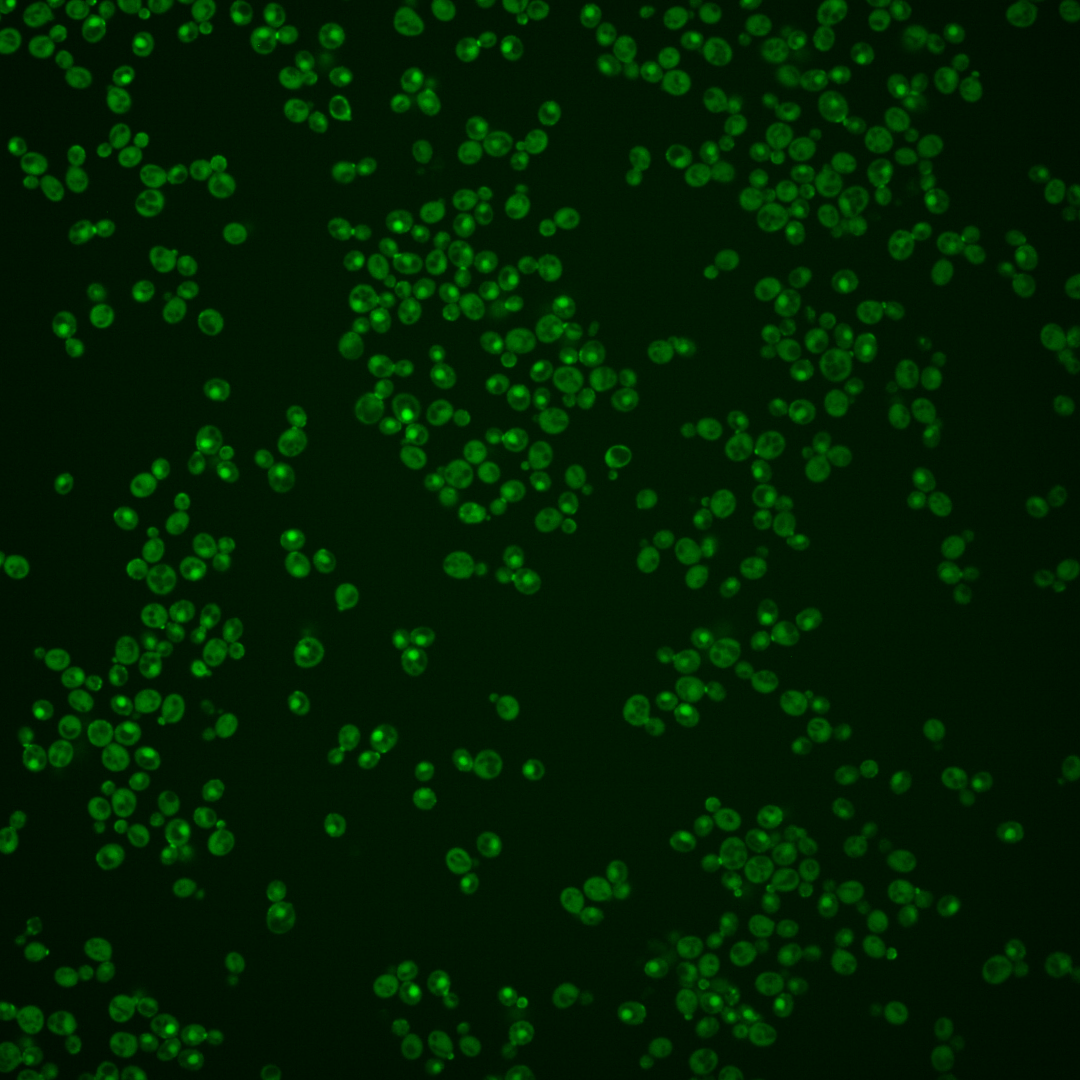
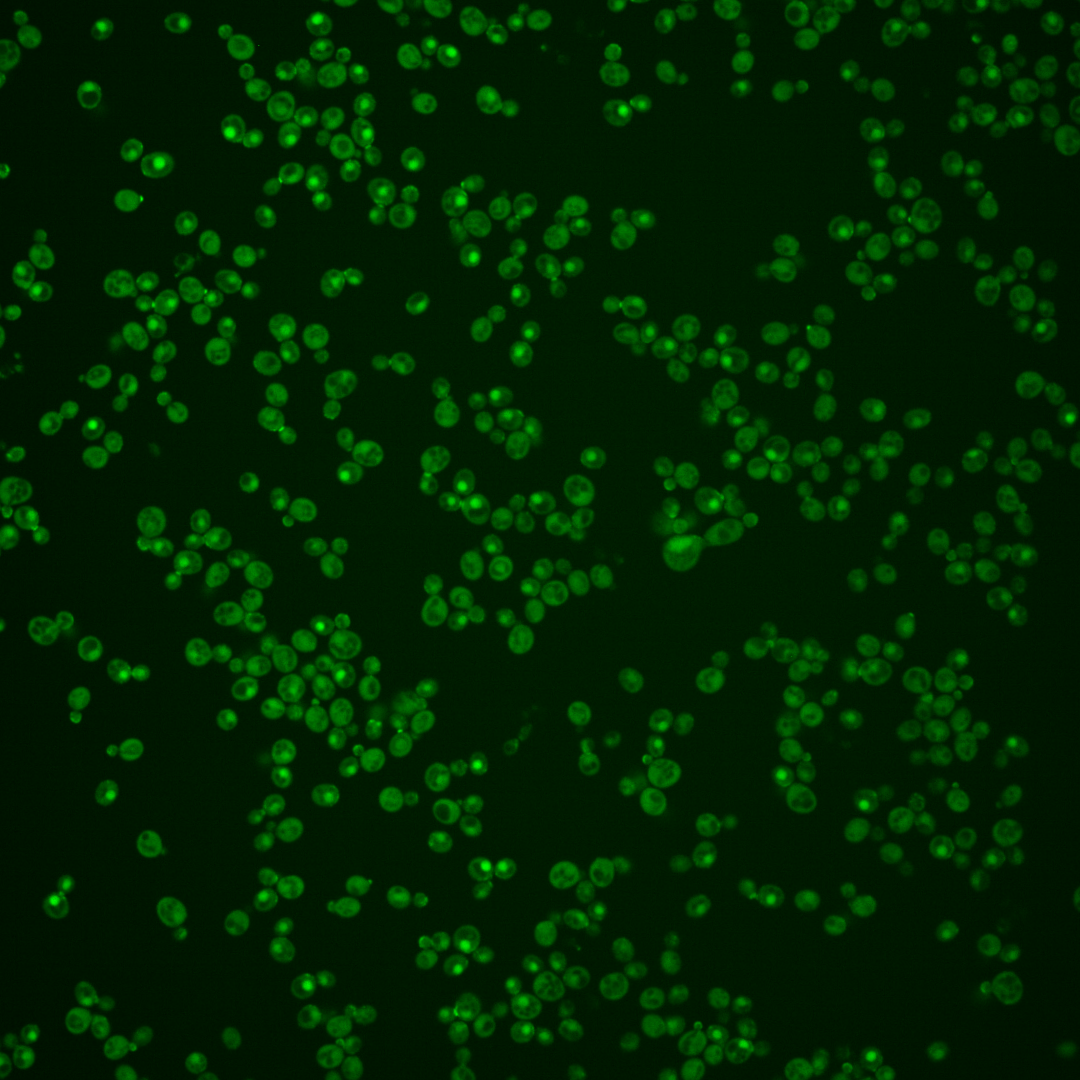
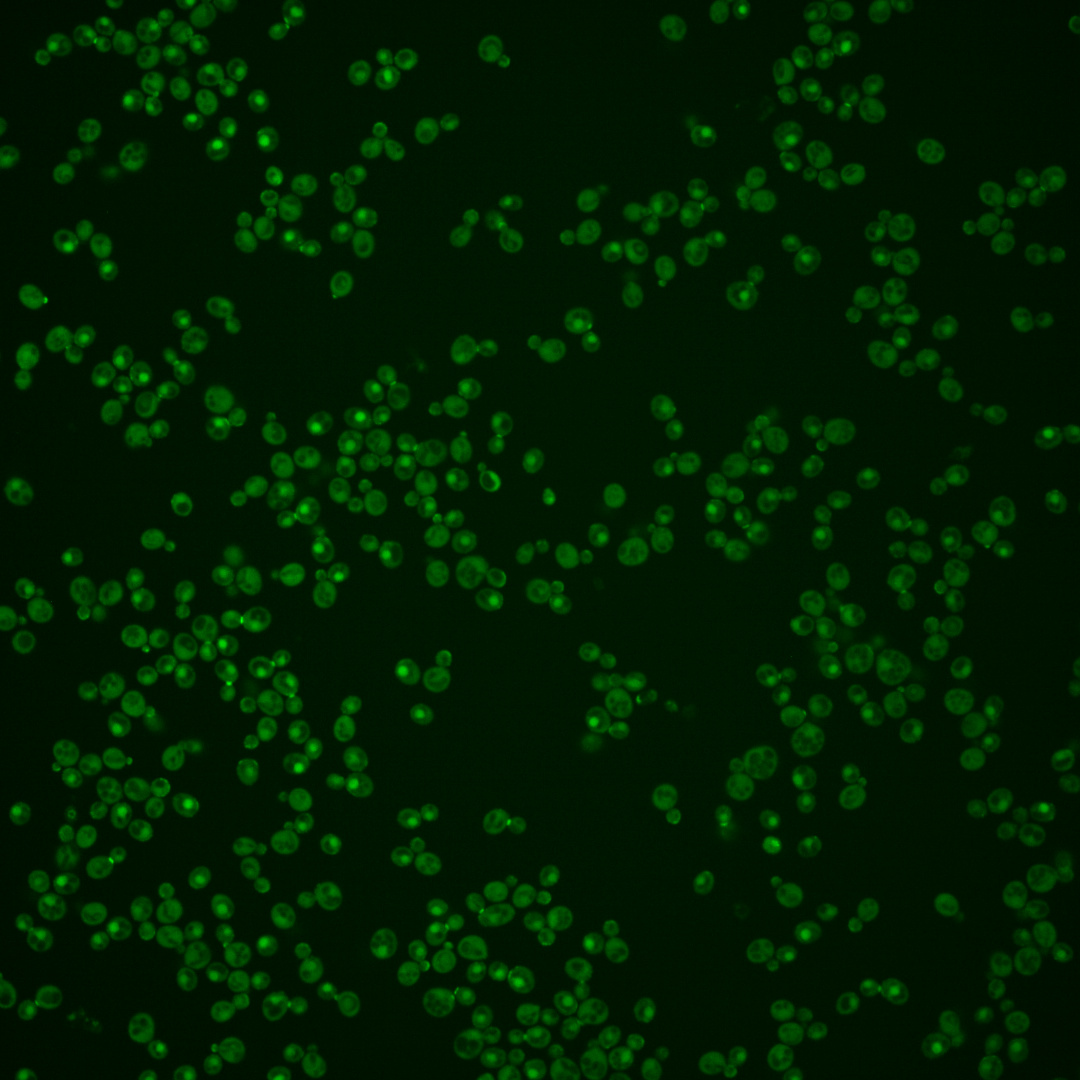

| Standard name | |
|---|---|
| Human Ortholog | |
| Description | Guanine nucleotide exchange factor (GEF) for Cdc42p; required for polarity establishment and maintenance, and mutants have morphological defects in bud formation and shmooing; relocalizes from nucleus to cytoplasm upon DNA replication stress; thermosensitivity of the cdc24-4 mutant in the presence of sorbitol is functionally complemented by human CDC42 |
Micrographs




















































































Sub-cellular Localization
Yeast GFP Assignment
Protein Abundance
Localization Change
External localization resources
| ensLOC | DeepLoc | |||||||||||||||||||||||
|---|---|---|---|---|---|---|---|---|---|---|---|---|---|---|---|---|---|---|---|---|---|---|---|---|
| Localization | WT1 | WT2 | WT3 | RAP60 | RAP140 | RAP220 | RAP300 | RAP380 | RAP460 | RAP540 | RAP620 | RAP700 | HU80 | HU120 | HU160 | rpd3Δ_1 | rpd3Δ_2 | rpd3Δ_3 | WT1 | WT2 | WT3 | AF100 | AF140 | AF180 |
| Cortical Patches | 15 | 13 | 11 | 24 | 35 | 24 | 22 | 28 | 17 | 4 | 7 | 17 | 20 | 29 | 21 | 44 | 20 | 18 | 17 | 14 | 11 | 11 | 13 | 5 |
| Bud | 13 | 15 | 15 | 13 | 22 | 22 | 33 | 28 | 30 | 15 | 28 | 32 | 21 | 17 | 16 | 19 | 7 | 10 | 20 | 35 | 34 | 45 | 59 | 62 |
| Bud Neck | 0 | 0 | 0 | 0 | 0 | 0 | 0 | 1 | 0 | 0 | 0 | 0 | 0 | 0 | 0 | 0 | 1 | 0 | 8 | 13 | 14 | 13 | 17 | 9 |
| Bud Site | 0 | 1 | 1 | 1 | 1 | 2 | 3 | 8 | 10 | 1 | 12 | 6 | 2 | 0 | 0 | 2 | 1 | 0 | – | – | – | – | – | – |
| Cell Periphery | 2 | 2 | 9 | 4 | 10 | 6 | 9 | 4 | 8 | 4 | 9 | 12 | 5 | 32 | 44 | 17 | 7 | 7 | 0 | 1 | 1 | 0 | 0 | 0 |
| Cytoplasm | 60 | 66 | 84 | 110 | 162 | 160 | 262 | 262 | 183 | 159 | 141 | 164 | 55 | 133 | 174 | 138 | 75 | 62 | 43 | 52 | 55 | 16 | 8 | 10 |
| Endoplasmic Reticulum | 6 | 3 | 13 | 12 | 13 | 17 | 21 | 23 | 11 | 6 | 6 | 8 | 18 | 23 | 29 | 17 | 6 | 2 | 4 | 1 | 4 | 10 | 15 | 14 |
| Endosome | 1 | 1 | 0 | 0 | 2 | 11 | 6 | 5 | 3 | 4 | 6 | 6 | 3 | 2 | 2 | 3 | 1 | 0 | 5 | 4 | 5 | 6 | 5 | 10 |
| Golgi | 1 | 0 | 0 | 0 | 0 | 0 | 0 | 1 | 0 | 0 | 0 | 0 | 0 | 0 | 0 | 3 | 2 | 3 | 3 | 0 | 0 | 0 | 0 | 3 |
| Mitochondria | 6 | 13 | 2 | 7 | 4 | 27 | 73 | 29 | 132 | 72 | 118 | 70 | 6 | 1 | 1 | 2 | 3 | 5 | 1 | 2 | 8 | 7 | 10 | 14 |
| Nucleus | 75 | 62 | 70 | 82 | 49 | 62 | 85 | 73 | 72 | 74 | 58 | 46 | 32 | 32 | 13 | 61 | 23 | 15 | 61 | 62 | 55 | 64 | 89 | 105 |
| Nuclear Periphery | 0 | 0 | 0 | 0 | 0 | 0 | 0 | 3 | 0 | 2 | 0 | 0 | 0 | 0 | 1 | 0 | 0 | 0 | 1 | 0 | 0 | 2 | 8 | 9 |
| Nucleolus | 0 | 1 | 0 | 0 | 0 | 1 | 0 | 3 | 2 | 0 | 2 | 2 | 0 | 0 | 0 | 0 | 2 | 0 | 0 | 0 | 0 | 0 | 2 | 3 |
| Peroxisomes | 0 | 0 | 0 | 0 | 1 | 1 | 1 | 2 | 0 | 0 | 1 | 0 | 1 | 1 | 1 | 1 | 0 | 1 | 0 | 0 | 0 | 0 | 0 | 1 |
| SpindlePole | 0 | 1 | 1 | 2 | 6 | 1 | 4 | 12 | 3 | 0 | 2 | 13 | 1 | 0 | 0 | 5 | 2 | 4 | 1 | 2 | 1 | 2 | 2 | 7 |
| Vac/Vac Membrane | 18 | 49 | 32 | 37 | 32 | 44 | 53 | 106 | 36 | 54 | 41 | 57 | 10 | 20 | 12 | 38 | 30 | 16 | 47 | 71 | 49 | 87 | 153 | 181 |
| Unique Cell Count | 182 | 201 | 208 | 260 | 288 | 327 | 499 | 520 | 400 | 347 | 336 | 359 | 148 | 242 | 260 | 288 | 154 | 113 | 223 | 264 | 247 | 274 | 393 | 447 |
| Labelled Cell Count | 197 | 227 | 238 | 292 | 337 | 378 | 572 | 588 | 507 | 395 | 431 | 433 | 174 | 290 | 314 | 350 | 180 | 143 | 223 | 264 | 247 | 274 | 393 | 447 |
Yeast GFP Assignment
Protein Abundance
| Screen | WT1 | WT2 | WT3 | RAP60 | RAP140 | RAP220 | RAP300 | RAP380 | RAP460 | RAP540 | RAP620 | RAP700 | HU80 | HU120 | HU160 | rpd3Δ_1 | rpd3Δ_2 | rpd3Δ_3 | AF100 | AF140 | AF180 |
|---|---|---|---|---|---|---|---|---|---|---|---|---|---|---|---|---|---|---|---|---|---|
| Mean Cell GFP Intensity (1e-4) | 8.9 | 7.7 | 7.8 | 7.3 | 7.8 | 6.4 | 6.3 | 6.6 | 5.5 | 5.5 | 5.2 | 6.0 | 8.4 | 8.5 | 8.4 | 10.1 | 10.0 | 9.5 | 8.2 | 8.2 | 8.8 |
| Std Deviation (1e-4) | 1.5 | 1.3 | 1.1 | 1.1 | 1.3 | 1.1 | 1.0 | 1.3 | 1.3 | 1.1 | 1.0 | 1.1 | 1.4 | 1.2 | 1.3 | 1.6 | 1.7 | 1.6 | 1.1 | 1.2 | 1.6 |
| Intensity Change (Log2) | – | – | – | -0.09 | 0.0 | -0.3 | -0.3 | -0.23 | -0.49 | -0.5 | -0.58 | -0.38 | 0.11 | 0.13 | 0.11 | 0.37 | 0.36 | 0.29 | 0.07 | 0.08 | 0.17 |
Localization Change
| Localization | RAP60 | RAP140 | RAP220 | RAP300 | RAP380 | RAP460 | RAP540 | RAP620 | RAP700 | HU80 | HU120 | HU160 | rpd3Δ_1 | rpd3Δ_2 | rpd3Δ_3 |
|---|---|---|---|---|---|---|---|---|---|---|---|---|---|---|---|
| Cortical Patches | 1.6 | 2.6 | 0.9 | -0.5 | 0.1 | -0.6 | -2.9 | -2.0 | -0.3 | 2.7 | 2.5 | 1.2 | 3.5 | 2.6 | 3.2 |
| Bud | -1.0 | 0.2 | -0.2 | -0.3 | -0.9 | 0.1 | -1.5 | 0.5 | 0.7 | 2.2 | -0.1 | -0.5 | -0.3 | -1.0 | 0.5 |
| Bud Neck | 0 | 0 | 0 | 0 | 0 | 0 | 0 | 0 | 0 | 0 | 0 | 0 | 0 | 0 | 0 |
| Bud Site | 0 | 0 | 0 | 0 | 0 | 0 | 0 | 0 | 0 | 0 | 0 | 0 | 0 | 0 | 0 |
| Cell Periphery | -1.8 | -0.5 | -1.7 | -1.9 | 0 | -1.7 | 0 | -1.0 | -0.6 | -0.5 | 3.3 | 4.3 | 0.8 | 0.1 | 0.7 |
| Cytoplasm | 0.4 | 3.5 | 1.9 | 2.9 | 2.4 | 1.3 | 1.2 | 0.4 | 1.2 | -0.6 | 3.1 | 5.7 | 1.7 | 1.6 | 2.5 |
| Endoplasmic Reticulum | -0.8 | -0.9 | -0.5 | -1.2 | -1.0 | -2.1 | -2.8 | -2.8 | -2.4 | 1.9 | 1.3 | 1.8 | -0.2 | -1.0 | -1.8 |
| Endosome | 0 | 0 | 0 | 0 | 0 | 0 | 0 | 0 | 0 | 0 | 0 | 0 | 0 | 0 | 0 |
| Golgi | 0 | 0 | 0 | 0 | 0 | 0 | 0 | 0 | 0 | 0 | 0 | 0 | 0 | 0 | 0 |
| Mitochondria | 0 | 0 | 3.6 | 5.4 | 2.8 | 9.0 | 6.6 | 9.3 | 6.4 | 0 | 0 | 0 | 0 | 0 | 0 |
| Nucleus | -0.5 | -4.3 | -3.8 | -4.9 | -6.0 | -4.3 | -3.2 | -4.4 | -5.9 | -2.5 | -5.2 | -8.1 | -3.1 | -4.0 | -4.0 |
| Nuclear Periphery | 0 | 0 | 0 | 0 | 0 | 0 | 0 | 0 | 0 | 0 | 0 | 0 | 0 | 0 | 0 |
| Nucleolus | 0 | 0 | 0 | 0 | 0 | 0 | 0 | 0 | 0 | 0 | 0 | 0 | 0 | 0 | 0 |
| Peroxisomes | 0 | 0 | 0 | 0 | 0 | 0 | 0 | 0 | 0 | 0 | 0 | 0 | 0 | 0 | 0 |
| SpindlePole | 0 | 0 | 0 | 0 | 0 | 0 | 0 | 0 | 2.3 | 0 | 0 | 0 | 0 | 0 | 0 |
| Vacuole | -0.3 | -1.4 | -0.6 | -1.8 | 1.6 | -2.4 | 0.1 | -1.1 | 0.2 | -2.5 | -2.4 | -4.0 | -0.7 | 1.0 | -0.3 |
External localization resources
Images






























Protein Concentration and Protein Localization Data
| R1 | R2 | R3 | ||||||||||||||||
|---|---|---|---|---|---|---|---|---|---|---|---|---|---|---|---|---|---|---|
| G1 Pre-START | G1 Post-START | S/G2 | Metaphase | Anaphase | Telophase | G1 Pre-START | G1 Post-START | S/G2 | Metaphase | Anaphase | Telophase | G1 Pre-START | G1 Post-START | S/G2 | Metaphase | Anaphase | Telophase | |
| Concentration | 4.6742 | 6.2011 | 5.2562 | 4.6801 | 4.1699 | 5.6563 | 3.4361 | 4.0399 | 3.651 | 3.5087 | 3.3638 | 4.1881 | 4.0222 | 4.4633 | 3.9927 | 4.1605 | 3.7392 | 4.1362 |
| Actin | 0.0504 | 0.0121 | 0.055 | 0.1083 | 0.0803 | 0.0048 | 0.0565 | 0.0084 | 0.0239 | 0.0219 | 0.0366 | 0.0062 | 0.0259 | 0.0135 | 0.0371 | 0.011 | 0.0187 | 0.0057 |
| Bud | 0.0096 | 0.011 | 0.109 | 0.0753 | 0.0127 | 0.0017 | 0.0067 | 0.0125 | 0.1187 | 0.0747 | 0.0521 | 0.0037 | 0.0052 | 0.0404 | 0.1512 | 0.0715 | 0.0195 | 0.0029 |
| Bud Neck | 0.0158 | 0.0167 | 0.0049 | 0.0037 | 0.0109 | 0.3911 | 0.019 | 0.0126 | 0.0069 | 0.0344 | 0.0123 | 0.34 | 0.0084 | 0.0101 | 0.01 | 0.0117 | 0.0281 | 0.2393 |
| Bud Periphery | 0.0215 | 0.0095 | 0.1771 | 0.3259 | 0.0182 | 0.0033 | 0.0141 | 0.0093 | 0.1618 | 0.1732 | 0.1193 | 0.0089 | 0.0079 | 0.0243 | 0.1819 | 0.1386 | 0.0349 | 0.0034 |
| Bud Site | 0.0165 | 0.1767 | 0.0578 | 0.0067 | 0.0109 | 0.0044 | 0.031 | 0.1142 | 0.0457 | 0.0092 | 0.0095 | 0.0062 | 0.0071 | 0.1301 | 0.0373 | 0.0086 | 0.016 | 0.0018 |
| Cell Periphery | 0.0078 | 0.0189 | 0.0061 | 0.0155 | 0.0028 | 0.0019 | 0.0017 | 0.0019 | 0.0043 | 0.0046 | 0.0077 | 0.0016 | 0.0007 | 0.0025 | 0.004 | 0.0063 | 0.0039 | 0.0007 |
| Cytoplasm | 0.1121 | 0.3196 | 0.3683 | 0.3347 | 0.4615 | 0.1361 | 0.0842 | 0.403 | 0.4561 | 0.4379 | 0.4211 | 0.1577 | 0.0502 | 0.3146 | 0.3555 | 0.5457 | 0.4104 | 0.0852 |
| Cytoplasmic Foci | 0.0233 | 0.0154 | 0.0076 | 0.0069 | 0.0133 | 0.0083 | 0.0162 | 0.0057 | 0.012 | 0.0062 | 0.0039 | 0.0036 | 0.0134 | 0.0043 | 0.0069 | 0.0024 | 0.0239 | 0.004 |
| Eisosomes | 0.0012 | 0.0001 | 0.0008 | 0.0007 | 0.0002 | 0.0001 | 0.0014 | 0 | 0.0001 | 0.0001 | 0.0001 | 0 | 0.0002 | 0.0001 | 0.0001 | 0 | 0.0001 | 0 |
| Endoplasmic Reticulum | 0.0132 | 0.0094 | 0.0082 | 0.0033 | 0.0072 | 0.0039 | 0.0108 | 0.0041 | 0.0065 | 0.014 | 0.0101 | 0.0032 | 0.0037 | 0.0028 | 0.0096 | 0.0155 | 0.0116 | 0.0034 |
| Endosome | 0.028 | 0.0127 | 0.0043 | 0.0053 | 0.0274 | 0.0142 | 0.0394 | 0.0033 | 0.0134 | 0.0291 | 0.0124 | 0.0098 | 0.0085 | 0.0013 | 0.009 | 0.0039 | 0.0171 | 0.0031 |
| Golgi | 0.0075 | 0.0027 | 0.0025 | 0.0081 | 0.0059 | 0.0025 | 0.0116 | 0.0007 | 0.0048 | 0.0063 | 0.0022 | 0.0032 | 0.0035 | 0.0004 | 0.0015 | 0.0004 | 0.0071 | 0.0006 |
| Lipid Particles | 0.0189 | 0.0016 | 0.002 | 0.0397 | 0.0071 | 0.0167 | 0.009 | 0.0002 | 0.001 | 0.0017 | 0.0009 | 0.005 | 0.0061 | 0.0002 | 0.0009 | 0.0002 | 0.0118 | 0.0005 |
| Mitochondria | 0.0318 | 0.0006 | 0.0155 | 0.0092 | 0.0793 | 0.0132 | 0.0156 | 0.0008 | 0.0225 | 0.0318 | 0.0414 | 0.0012 | 0.0078 | 0.0012 | 0.0024 | 0.0031 | 0.0058 | 0.0007 |
| None | 0.0914 | 0.0457 | 0.0715 | 0.0031 | 0.0024 | 0.0016 | 0.0177 | 0.0033 | 0.0047 | 0.0038 | 0.0022 | 0.0006 | 0.0062 | 0.0091 | 0.0104 | 0.0026 | 0.0263 | 0.0009 |
| Nuclear Periphery | 0.0205 | 0.0054 | 0.005 | 0.003 | 0.006 | 0.0089 | 0.0281 | 0.009 | 0.0073 | 0.0145 | 0.019 | 0.0052 | 0.0109 | 0.007 | 0.0119 | 0.0143 | 0.014 | 0.011 |
| Nucleolus | 0.0072 | 0.0029 | 0.0013 | 0.0004 | 0.0012 | 0.0074 | 0.003 | 0.0023 | 0.0015 | 0.001 | 0.0029 | 0.004 | 0.0075 | 0.0027 | 0.0027 | 0.0012 | 0.0034 | 0.0058 |
| Nucleus | 0.4777 | 0.3162 | 0.0754 | 0.0052 | 0.1726 | 0.3631 | 0.6121 | 0.395 | 0.0805 | 0.1116 | 0.2263 | 0.4305 | 0.7937 | 0.4176 | 0.1316 | 0.1364 | 0.2922 | 0.6166 |
| Peroxisomes | 0.0079 | 0.0013 | 0.0077 | 0.0242 | 0.0698 | 0.0033 | 0.0055 | 0.0005 | 0.0019 | 0.0008 | 0.0004 | 0.0007 | 0.0061 | 0.0009 | 0.0012 | 0.0002 | 0.0194 | 0.0002 |
| Punctate Nuclear | 0.0135 | 0.0078 | 0.0017 | 0.0031 | 0.0025 | 0.0055 | 0.0051 | 0.0044 | 0.0023 | 0.0056 | 0.0095 | 0.0035 | 0.0208 | 0.0072 | 0.0061 | 0.0015 | 0.022 | 0.0096 |
| Vacuole | 0.0196 | 0.0132 | 0.0166 | 0.0159 | 0.0064 | 0.0071 | 0.0088 | 0.0083 | 0.0209 | 0.0148 | 0.0092 | 0.0048 | 0.0046 | 0.0089 | 0.0261 | 0.0227 | 0.0127 | 0.0043 |
| Vacuole Periphery | 0.0046 | 0.0005 | 0.0016 | 0.0017 | 0.0014 | 0.0009 | 0.0026 | 0.0004 | 0.0029 | 0.0029 | 0.0012 | 0.0005 | 0.0016 | 0.0007 | 0.0026 | 0.0022 | 0.0011 | 0.0005 |
Sequencing Data
| R1 | R2 | |||||||||
|---|---|---|---|---|---|---|---|---|---|---|
| G1 Post-START | S/G2 | Metaphase | Anaphase | Telophase | G1 Post-START | S/G2 | Metaphase | Anaphase | Telophase | |
| Gene Expression | 16.7769 | 19.6122 | 19.4041 | 24.348 | 17.0112 | 20.2071 | 24.1069 | 24.537 | 22.8765 | 26.3009 |
| Translational Efficiency | 0.7819 | 0.8126 | 0.7651 | 0.6451 | 0.8733 | 0.7822 | 0.75 | 0.6945 | 0.7905 | 0.6782 |
Hit Data
| Dataset | Hit |
|---|---|
| Protein Concentration | ✘ |
| Protein Localization | ✔ |
| Gene Expression | ✘ |
| Translational Efficiency | ✘ |
Endocytosis
| Temp | Actin Patch (Sac6-tdTomato) | Cortical Patch (Sla1-GFP) | Late Endosome (Snf7-GFP) | Vacuole (Vph1-GFP) |
|---|---|---|---|---|
| 37℃ | ||||
| RT |
Cell Cycle Omics
CYCLoPs (Cdc24-GFP)
| Gene / Allele | Actin Patch (Sac6-tdTomato) | Cortical Patch (Sla1-GFP) | Late Endosome (Snf7-GFP) | Vacuole (Sac6-tdTomato) |
|---|
| Gene | Images |
|---|
| Gene | Images |
|---|
Images are not yet available
Images are not yet available